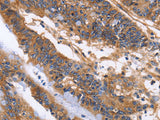
ITGB1 Polyclonal Antibody Store at -20°C

ITGB1 Polyclonal Antibody Store at -20°C
SKU: E-AB-10403-200
ITGB1 Polyclonal Antibody Store at -20°C
| SKU # | E-AB-10403 |
| Reactivity | Human, Mouse, Rat |
| Host | Rabbit |
| Applications | WB, IHC |
Product Details
| Isotype | IgG |
| Host | Rabbit |
| Reactivity | Human, Mouse, Rat |
| Applications | WB, IHC |
| Clonality | Polyclonal |
| Immunogen | Recombinant protein of human ITGB1 |
| Abbre | ITGB1 |
| Synonyms | CD29, FNRB, Fibronectin receptor subunit beta, GP IIa, GPIIA, Glycoprotein IIa, ITB1, ITGB, Integrin, Integrin beta-1, Integrin subunit beta 1, MSK12), antigen CD29 includes MDF2, beta 1 (fibronectin receptor, beta polypeptide, beta1 integrin, integrin VLA-4 beta subunit |
| Swissprot | |
| Calculated MW | 88 kDa |
| Cellular Localization | Cell membrane, sarcolemma. Cell junction. In cardiac muscle, isoform 5 is found in costameres and intercalated disks and Cell membrane. Cell projection, invadopodium membrane. Cell projection, ruffle membrane. Recycling endosome. Melanosome. Cleavage furrow. Cell projection, lamellipodium. Cell projection, ruffle. Cell junction, focal adhesion. Cell surface. Isoform 2 does not localize to focal adhesions. Highly enriched in stage I melanosomes. Located on plasma membrane of neuroblastoma NMB7 cells. In a lung cancer cell line, in prometaphase and metaphase, localizes diffusely at the membrane and in a few intracellular vesicles. In early telophase, detected mainly on the matrix-facing side of the cells. By mid-telophase, concentrated to the ingressing cleavage furrow, mainly to the basal side of the furrow. In late telophase, concentrated to the extending protrusions formed at the opposite ends of the spreading daughter cells, in vesicles at the base of the lamellipodia formed by the separating daughter cells. Colocalizes with ITGB1BP1 and metastatic suppressor protein NME2 at the edge or peripheral ruffles and lamellipodia during the early stages of cell spreading on fibronectin or collagen. Translocates from peripheral focal adhesions sites to fibrillar adhesions in a ITGB1BP1-dependent manner. Enriched preferentially at invadopodia, cell membrane protrusions that correspond to sites of cell invasion, in a collagen-dependent manner. Localized at plasma and ruffle membranes in a collagen-independent manner. |
| Concentration | 0.5 mg/mL |
| Buffer | Phosphate buffered solution, pH 7.4, containing 0.05% stabilizer and 50% glycerol. |
| Purification Method | Affinity purification |
| Research Areas | Cancer, Developmental Biology, Microbiology, Neuroscience, Signal Transduction, Stem Cells |
| Conjugation | Unconjugated |
| Storage | Store at -20°C Valid for 12 months. Avoid freeze / thaw cycles. |
| Shipping | The product is shipped with ice pack,upon receipt,store it immediately at the temperature recommended. |
Related Reagents
| Applications | Recommended Dilution |
| WB | 1:500-1:2000 |
| IHC | 1:50-1:200 |
Background
Integrins are heterodimeric proteins made up of alpha and beta subunits. At least 18 alpha and 8 beta subunits have been described in mammals. Integrin family members are membrane receptors involved in cell adhesion and recognition in a variety of processes including embryogenesis, hemostasis, tissue repair, immune response and metastatic diffusion of tumor cells. This gene encodes a beta subunit. Multiple alternatively spliced transcript variants which encode different protein isoforms have been found for this gene.